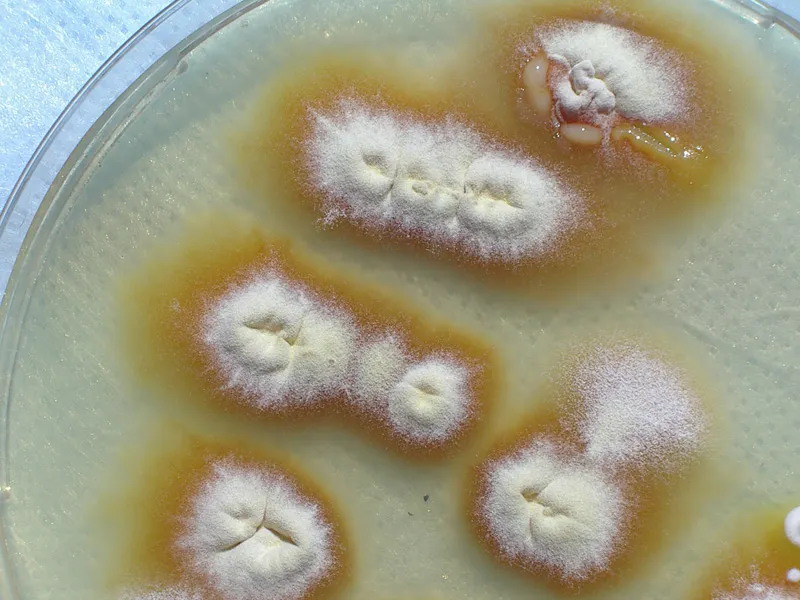
Foto

Reto del mes de Agosto 2010
Mauricio 06/08/2010 15:10:29
Hola. Continuando con el reto de Agosto el ganador de Julio Blopez, escogio como tema para este mes: [color=#ff9900]Objetivos de Color Anaranjado[/color]
- La fotografía no tiene que ser 100% anaranjado, pero su objetivo principal debe de tener gran cantidad de color anaranjado.
- La fotografía no debe ser manipulada digitalmente para lograr el anaranjado o efectos anaranjados
- Subir la fotografía respondiendo este tema para que esta participe, si se sube en otro tema no es valida
- 3 Fotografías por usuario
- No hacer comentarios en este tema
RE: Reto del mes de Agosto 2010
rickyguide 07/08/2010 00:11:27
Bueno ahí voy con mis 3 aportes.

Perth Australia

Tortuguero, Costa Rica

Australia
RE: Reto del mes de Agosto 2010
Luis Vargas 07/08/2010 15:57:05
[color=#FFA500]Naranja...[/color]

Costa Rica

Costa Rica

brbrbr
RE: Reto del mes de Agosto 2010
monicaahman 08/08/2010 15:33:28

Bogota - Colombia

Orlando- florida USA
RE: Reto del mes de Agosto 2010
Ãngel González Quesada 08/08/2010 15:46:32
No sé si esta fotografía es adecuada, en todo caso imagino que los moderadores pueden suprimirla. Espero que les guste.

Llucmajor, Mallorca.
Desce mi terraza, Mallorca.

RE: Reto del mes de Agosto 2010
Jorge Chinchilla 09/08/2010 01:57:15
[align=center][size=small]Chorchín[/align]

La Garita de Alajuela, Costa Rica

Playa Tamarindo, Santa Cruz, Guanacaste
Sorpresa en la selva
gerardo colaleo 09/08/2010 06:10:36

Amazonia lodge- Peru
RE: Reto del mes de Agosto 2010
Marco Vinicio 09/08/2010 09:21:05
[align=right]

Río Macho. Orosi, Costa Rica

Río Macho. Orosi, Costa Rica

Parque Nacional Tapantí- Macizo de la Muerte
RE: Reto del mes de Agosto 2010
Gonzalo Marin 12/08/2010 16:50:28
Laboratorio de Microbiologia

Desamparados, C.R.
RE: Reto del mes de Agosto 2010
Azucena Briones Muñoz 13/08/2010 21:15:29
Tigridia Pavonia ( oceloxochitl o "flor del Jaguar )

En mi jardin
RE: Reto del mes de Agosto 2010
Azucena Briones Muñoz 16/08/2010 19:13:12
Gongora galeata.

En mi jardin

En mi jardin
RE: Reto del mes de Agosto 2010
chivizcoyo 17/08/2010 17:45:25
Tlaconete

Xalapa Ver.

La Mancha. Actopan Ver.
RE: Reto del mes de Agosto 2010
FASB 19/08/2010 16:31:03
Ante la falta de tiempo, mi aporte

Santiago, San Ramón de Alajuela



































